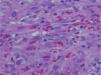

Sr. Director:
El sarcoma de Kaposi (SK) es un tumor de células vasculares de origen multifocal descrito por Moritz Kaposi en 18721. La forma clásica afecta principalmente a las extremidades inferiores de personas de edad avanzada en el área mediterránea2. La afectación aislada del pene es rara y usualmente ocurre en pacientes con sida; puede ser la primera manifestación en un 2–3 % de los casos, siendo extremadamente infrecuente en pacientes con el virus de la inmunodeficiencia humana (VIH) negativos3. En los últimos 20 años sólo se han descrito 15 casos de pacientes inmunocompetentes con SK primario del pene en la literatura inglesa4.
Presentamos el caso de un varón de 80 años, sin antecedentes de interés, que consultó por presentar una tumoración asintomática de rápido crecimiento a nivel del pene de dos semanas de evolución. El paciente no refería historia de traumatismos locales, inmunosupresión, adicción a drogas intravenosas, transfusiones sanguíneas ni relaciones homosexuales. A la exploración física se apreciaba un nódulo rosado de consistencia blanda y base pediculada de 10 mm de diámetro a nivel del surco balanoprepucial. Además, presentaba una segunda lesión bien delimitada de menor tamaño (4 mm de diámetro) de coloración rojo-violácea indolora que el paciente refirió tener desde hacía varios años (fig. 1). No se evidenciaron adenopatías inguinales, hepatoesplenomegalia ni otras lesiones mucocutáneas. El estudio histológico de la lesión de mayor tamaño mostró una proliferación tumoral multinodular constituida por células fusiformes de núcleo alargado, hipercromático, con mitosis ocasionales, dispuestas en haces formando hendiduras con presencia de hematíes (figs. 2 y 3). En diversas áreas se apreciaban cuerpos globulares eosinófilos y depósitos de hemosiderina. Las tinciones de inmunohistoquímica fueron positivas para el CD31 y el CD34. La extirpación de la segunda lesión presentó alteraciones histopatológicas similares. Los estudios analíticos realizados: hemograma, bioquímica, estudio de la coagulación y poblaciones linfocitarias no mostraron datos relevantes. La serología para el VIH fue negativa en dos determinaciones. Finalmente, se estableció el diagnóstico de SK primario del pene en paciente inmunocompetente. Tras un año de seguimiento, el paciente permanece estable y sin nuevas lesiones.
La patogenia del SK es desconocida, aunque sus características epidemiológicas apuntan a una probable causa infecciosa. El virus herpes humano 8 (VHH-8) es el agente implicado en la hiperplasia vascular, considerándose un factor necesario pero no suficiente. La alta seroprevalencia para el VHH-8 en individuos con actividad sexual de alto riesgo apoyaría esta vía de transmisión de la infección en adultos, sin embargo, la detección de anticuerpos frente al VHH-8 en niños sugiere otras vías no sexuales de transmisión, probablemente la saliva2,3.
Clínicamente el SK del pene se caracteriza por nódulos indoloros de coloración rojo-violácea. Otras formas de presentación menos frecuentes son en forma de múltiples pápulas, placas o tumores pedunculados de rápido crecimiento3. En la mayoría de los casos existen una o dos lesiones aisladas5. La localización más frecuente en el área genital es el glande, aunque también pueden afectar al prepucio, surco coronal, meato uretral y escroto4.
El patrón histológico del SK del pene es similar al que se puede observar en otras localizaciones anatómicas. En la fase tumoral se aprecian nódulos compuestos por una red de espacios vasculares con contenido hemático y fascículos de células fusiformes con citoplasma bien definido y núcleo ovoide. Característicamente las células fusiformes son CD34 positivas6. En algunas áreas podría plantearse el diagnóstico diferencial con el granuloma piogénico y el hemangioendotelioma de células fusiformes. La proliferación tumoral fusocelular con presencia de células atípicas y formación de hendiduras no apoyaría el diagnóstico de granuloma piogénico. En el hemangioma de células fusiformes destacaría la presencia de una marcada vacuolización citoplásmica y ausencia de atipias celulares7.
El tratamiento del SK primario del pene incluye extirpación quirúrgica local, radioterapia, electrocoagulación, terapia con láser e inyección intralesional de interferón alfa, aunque no existe una guía de tratamiento establecida. Se recomienda la cirugía para lesiones pequeñas y solitarias. La radioterapia se emplea en lesiones de mayor extensión y la quimioterapia sistémica se reserva para casos más avanzados con afectación visceral o lesiones generalizadas. El curso clínico del SK primario del pene es variable y las recurrencias locales son infrecuentes si el tumor primario se elimina completamente3.
Nos gustaría destacar que, aunque el SK primario del pene en sujetos inmunocompetentes es una entidad extremadamente infrecuente, debe ser considerada en el diagnóstico diferencial de lesiones no específicas del área genital. El examen histológico es aconsejable en los casos dudosos sin rasgos clínicos característicos para establecer el diagnóstico definitivo.